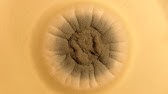

The biggest hypocrite: Pixelated Apollo
01:13:50
https://www.youtube.com/watch?v=n5OoajO49Gk
概要
TLDRThe video emphasizes the significance of mental health awareness and provides various strategies to enhance mental well-being. It highlights the impact of mental health on daily life and encourages viewers to prioritize their mental health. The video also offers insights into common mental health disorders and ways to support individuals facing these challenges.
収穫
- 🧠 Mental health awareness is crucial for overall well-being.
- 💪 Regular exercise can significantly improve mental health.
- 🥗 A balanced diet contributes to better mental health.
- 🧘♂️ Mindfulness practices help reduce stress and anxiety.
- 🤝 Supporting others with empathy is essential.
- 📚 Seeking professional help is a sign of strength.
- 🔍 Understanding common disorders aids in awareness.
- 💬 Open conversations about mental health are important.
- 🌱 Prioritizing mental health leads to a better quality of life.
- 🛠️ Implementing strategies can enhance mental resilience.
マインドマップ
ビデオQ&A
What is mental health awareness?
Mental health awareness refers to the understanding and recognition of mental health issues and the importance of mental well-being.
Why is mental health important?
Mental health is crucial as it affects how we think, feel, and act, influencing our overall quality of life.
What are some strategies for improving mental health?
Strategies include regular exercise, maintaining a balanced diet, practicing mindfulness, and seeking professional help when needed.
How can I support someone with mental health issues?
You can support them by listening, being empathetic, encouraging them to seek help, and being patient.
What are common mental health disorders?
Common disorders include anxiety, depression, bipolar disorder, and schizophrenia.
ビデオをもっと見る

Hematoxylin & Eosin Staining Procedure, Principle with Video Lecture

How to Debloat your Face (Full Guide)
Our Body is a Planet

Pharmacology Basics: Ophthalmic Medication

How to Be More Visionary As A Team Leader | Executive Coaching

ANALYTICAL EXPOSITION TEXT LENGKAP | KELAS 11 (XI) | PURPOSE, STRUCTURE, LANGUAGE FEATURE
AIを活用したYouTubeの無料動画要約に即アクセス!
字幕
en
オートスクロール:
タグ
- mental health
- awareness
- well-being
- strategies
- support
- disorders
- exercise
- mindfulness
- diet
- empathy